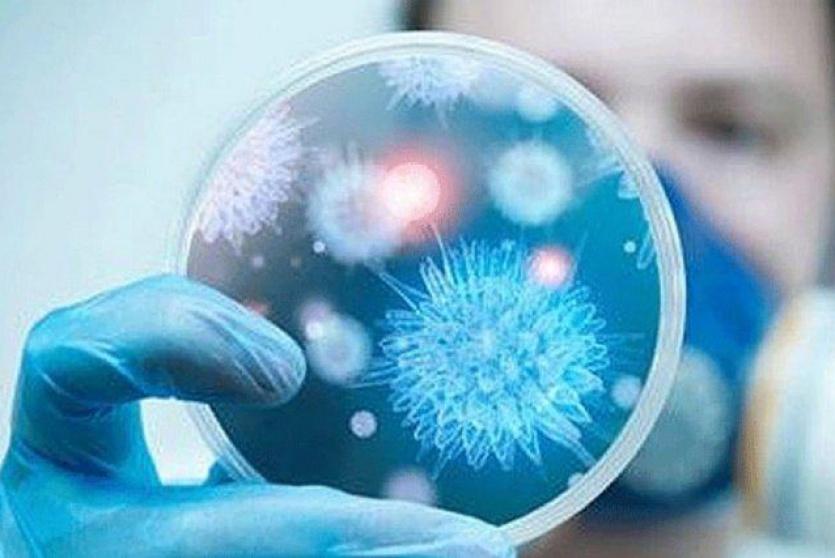

شاهد: مصابان بكورونا.. عجوز صيني يعتني بزوجته "
أصيب رجل صيني يبلغ من العمر 87 عاما، بمرض كورونا، ولكن إصابته لم تمنعه من زيارة زوجته المصابة أيضا بالمرض، في الجناح المجاور له، لتقديم يد العون والدعم لها.
متكئا على ذاته، وممسكا بزجاجة الضخ التي تساعده على الحياة، دخل على زوجته بحسب الموقع الصيني "بيبولز دايلي تشينا"، وأطعمها الغذاء بواسطة "تشوبسكتس"، وسقاها الماء، وظل بجانبها حتى يهون عليها المرض.
وأشار الموقع أن الزوجة لا تستطيع النهوض من الفراش والقيام بأي نشاطات، ويبدو هذا المشهد المؤثر، معبرا عن العلاقات الإنسانية، ومتانتها حتى في أحلك الظروف.
يُذكر أن لفيروس كورونا مجموعة من الأعراض تتراوح بين نزلات البرد الشائعة، وأخرى شديدة مثل تلك الناجمة عن المتلازمة التنفسية الحادة سارس، ومتلازمة الشرق الأوسط التنفسية ميرس.
I’ll love you forever, every single day of forever: An 87-yr-old man diagnosed with #COVID19 held an infusion bottle to visit his wife, also a #COVID19 patient, from the ward next door and patiently gave her water and food. Hope you recover soon! pic.twitter.com/LXH1AxINsU
— People's Daily, China (@PDChina) ١٢ فبراير ٢٠٢٠